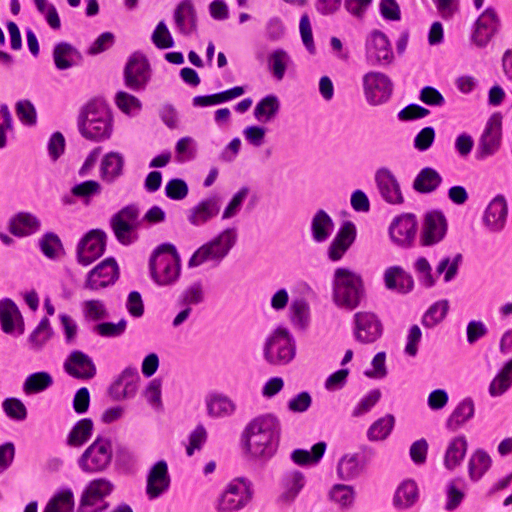

LoRA text2image fine-tuning - RiddleHe/SD14_pathology_lora
These are LoRA adaption weights for CompVis/stable-diffusion-v1-4. The weights were fine-tuned on the None dataset. You can find some example images in the following.
![]() |
![]() |
![]() |
Intended uses & limitations
How to use
pipe = DiffusionPipeline.from_pretrained(
"CompVis/stable-diffusion-v1-4", torch_dtype=torch.float16
)
pipe.load_lora_weights("RiddleHe/SD14_pathology_lora")
pipe.to('cuda')
prompt = "A histopathology image of breast cancer tissue"
Limitations and bias
[TODO: provide examples of latent issues and potential remediations]
Training details
This model is trained on 28216 breast cancer tissue images from the BRCA dataset.
- Downloads last month
- 8
Model tree for RiddleHe/SD14_pathology_lora
Base model
CompVis/stable-diffusion-v1-4